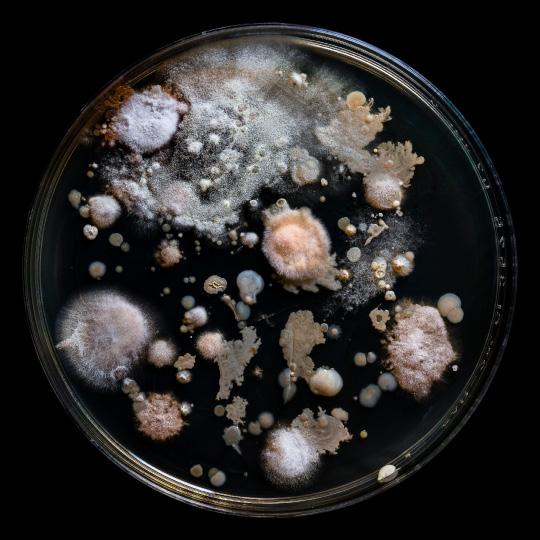

5 minute read
Die Rückeroberung der verlassenen Stadt
Fotografien & Augmented Reality
Vita
Advertisement
David Alscher ist 29 Jahre alt und ein in Wien und Niederösterreich lebender Werbefotograf.
Artist Statement
„Die Bilderserie „Widerstand der Natur: Die Rückeroberung der verlassenen Stadt“ erkundet das faszinierende Zusammenspiel zwischen der Natur und der vom Menschen geschaffenen Umgebung. Es wird eine verlassene Stadt eingefangen, in der sich Pflanzen beharrlich ihren Raum von den einst belebten Gebäuden zurückerobern. Das Hauptaugenmerk liegt dabei auf der überwältigenden Kraft der Natur, die trotz des Verfalls und der Vernachlässigung ihre Stärke und Schönheit zur Geltung bringt. Die Bilder erinnern uns daran, dass die Natur einen Weg findet, sich selbst zu heilen und zu regenerieren, selbst in den entlegensten und unwirtlichsten Ecken der Welt. Indem wir die Schönheit und den Widerstand der Natur inmitten des Verfalls betrachten, können wir eine tiefere Verbindung zu unserer eigenen Natur herstellen. Es ist ein Aufruf zur Achtsamkeit und zum Respekt gegenüber der Natur, die uns umgibt.
Diese Bilderserie ruft aber auch eine gewisse Melancholie hervor, da sie uns daran erinnert, dass menschliche Zivilisationen vergänglich sind. Sie zeigt uns, wie die Natur langsam, aber sicher das Ruder übernimmt und die Spuren der menschlichen Präsenz verwischt. Doch gleichzeitig lässt sie auch Raum für Hoffnung und Bewunderung für die Schönheit, die in dieser Widerstandsfähigkeit liegt.
Aufgenommen wurden die Bilder in der ungarischen Gemeinde ‚Szentkirályszabadja‘, in deren nordöstlichen Teil in den 1960er Jahren eine sowjetische Kasernenstadt entstand, in der mehrere tausend russische und ukrainische Soldaten mit ihren Familien lebten. Neben Wohngebäuden gab es Kindergärten, Schulen, Bibliothek, Krankenhaus, Kino und Theater, Post, Geschäfte, Restaurants und Kneipen. Nach dem Zusammenbruch der Sowjetunion wurde der Stützpunkt von den ehemaligen Bewohnern verlassen.“
- David Alscher

Augmented Reality

Durch die Nutzung von Artivive sieht man als Betrachter dreidimensionale Pflanzen aus den Bildern hervorragen, die sich, wie jene Pflanzen in den Motiven, ihren Platz zurückholen und die Fotografien überwuchern.
Einblicke in die AR-Erweiterung

Gerhard Fibi


Kontakt: www.fibi-foto.at | fibi.gerhard@gmail.com
Scenery 1100110
Fotografien & Augmented Reality
Vita
Gerhard Fibi ist 34 Jahre alt und gelernter Fotokaufmann & Fotolaborant in diversen Wiener Betrieben. Weiters absolvierte er ein Kunstgeschichte Bachelor-Studium an derUniversität Wien und studiert derzeit im Masterstudiengang Digital Design an der FH in St. Pölten.
Artist Statement
„Für die Ausstellung in der Fine Art Galerie in Traismauer habe ich drei ‚promto(Foto)grafien‘ mitels künstlicher Intelligenz erschaffen. Bei meiner Arbeit habe ich ausschließlich mit Computerprogrammen gearbeitet, die K.I unterstützt sind.
Dies wird anhand des AR-Video-Teil im Hintergrund noch unterstrichen. Hier wird gezeigt, dass Textpassagen, das „Promt Engeneering“, alles von Computerhand übernommen worden ist. Für die Entstehung der Bilder wurde keine Digitalkamera benötigt, um Ergebnisse zu erzielen. Es wurde nur mit KI-basierten Sprach - und Kunstmodellen gearbeitet, ganz im Gegenteil zu der eigentlichen Aufgabe eines/einer jeden (anlogen oder digitalen) Fotograf:in stehend. Jede Fotografie hinterlässt auch einen ökologischen Fußabdruck, so wurden bei der Analogfotografie Rohstoffe wie Kupfer, Silber und Papier verwendet, um später betrachtet werden zu können. Bei der digitalen Variante benötigen wir elektronische Bauteile, wie lichtempfindliche Fotosensoren, fotografische Datenspeicher und viele weitere Rohstoffe, die für die Verarbeitung einer digitalen Aufnahme notwendig sind, wie zum Beispiel Kunststoff oder Magnesium für das Kameragehäuse selbst. Für die letzte und von mir verwendete Variante brauche ich alle nötigen Ressourcen eines funktionierenden Computers, samt stabiler Internetverbindung und funktionierender Software. Aus dieser Perspektive betrachtet, bedeutet das, dass Fotografieren, egal für welchen Zweck und welcher Entstehungsprozess durchlaufen wurde, immer an Ressourcen und Rohstoffe gebunden ist, die von unserem Planeten Erde produziert und abgebaut wurden. Ist Fotografie als Widerstand gegen die Natur zu sehen? Ist Fotografie ohne Kamera noch Fotografie?“

Augmented Reality
Dies wird in einem „making of Video“ festgehalten und dokumentiert. Das Video wird für den AR-Teil der „Promtografien“ verwendet. Hier können die Besucher:innen der Ausstellung ihr Smartphone/Tablet über das Bild halten und mir dabei zusehen, wie ich Midjourney und ChatGPT nutze, um per Texteingabe Befehle erteile, um ästhetisch wirkende Bilder erzeugen zu lassen. Das Video für die AR wird mit dem Bild „ Scenery 1001“ starten. Hier finden die Besucher den Hinweis, dass es sich um ein K.I generiertes Bild handelt. Dann wird der Prozess der Entstehung durchlaufen. Das Video endet wieder mit dem selben Bild.Das Thema „Widerstand der Natur“ spiegelt sich in den generierten-fiktionalen Landschaftsaufnahmen wider. Diese zeigen mystische Landschaften, die gerade kurz davorstehen, in einem Unwetter zu versinken. Die Natur wehrt sich und zeigt uns anhand des Klimas und den stärker werdenden Naturgewalten, dass wir nur eine Erde haben und beginnen sollten, diese mehr zu schonen.
Einblicke in die AR-Erweiterung

Marlies Riepl

Kontakt: marliesriepl.com | @marliesriepl
apPETite
Fotografien & Augmented Reality
Vita
Marlies Riepl betrachtet sich als Fotografin und digitale Gestalterin. Sie wurde 1999 in Krems an der Donau geboren und seit 2014 widmet sie sich mit Leidenschaft der Erstellung visueller Inhalte. In ihren Werken legt sie besonderen Wert auf präzise und detailgetreue Ausführung, während sie gleichzeitig darauf bedacht ist, die Geschichten hinter den Bildern zu erzählen.
Artist Statement
„Jährlich werden weltweit etwa 390 Millionen Tonnen Kunststoff produziert, von denen ein beträchtlicher Teil in unserer Umwelt landet. Plastik schwimmt in unseren Meeren, liegt in Wäldern, auf Bergen oder an Straßenrändern. Hinterlassener Plastikmüll stellt ein großes Problem dar, das weitreichende Konsequenzen für unsere Ökosysteme hat. Eine einzelne PET-Flasche benötigt etwa 450 Jahre bis diese zersetzt ist. Besonders problematisch sind die in Kunststoffen enthaltenen Additive, die in die Umwelt und in den menschlichen Körper gelangen können und unser Hormonsystem beeinflussen. Auch für Lebewesen in der Natur kann Plastikmüll fatal sein. Oft wird er mit Nahrung verwechselt, wodurch Tiere Schaden nehmen oder daran zugrunde gehen, indem sie sich darin verfangen. Angesichts dieser Problematik hat die Forschung zuletzt ihre Hoffnungen vermehrt auf Mikroorganismen wie Bakterien und Pilze gesetzt, die in der Lage sind, Kunststoffe und Mikroplastik aus unserer Umwelt abzubauen. Der Stoffwechsel dieser Organismen hat sich an die neue, von Plastik verschmutzte Umgebung angepasst, sodass sie bestimmte Kunststoffarten durch die Produktion spezifischer Enzyme abbauen können. Allerdings befindet sich die Forschung auf diesem Gebiet noch in den Anfängen und sollte daher nicht als Allheilmittel gegen die weltweite Plastik- und Müllverschmutzung angesehen werden.
‚apPETite‘ setzt sich mit diesen neuesten Forschungsergebnissen auseinander und veranschaulicht die bedeutende Rolle von Mikroorganismen, insbesondere Bakterien und Pilzen, als natürlicher Widerstand gegenüber Plastikmüll in der Natur. Die Serie präsentiert eindrucksvolle Makroaufnahmen von neun Bakterienkulturen, die aus entommenen Proben von gefundenem Plastikmüll gezüchtet wurden. Diese Bilder geben einen einzigartigen Einblick in die vielfältigen Formationen der Mikroorganismen und verdeutlichen die außergewöhnliche Fähigkeit der Natur, sich dem menschlichen Handeln entgegenzusetzen.“






Augmented Reality
Mithilfe von Augmented Reality können die Besucher:innen in die Geschichte und den Kontext hinter den einzelnen Bakterienkulturen eintauchen. Sie erhalten visuelle Einblicke zu dem Plastikmüll hinter den Bakterienkulturen und dessen Fundort. Durch AR wird auch der Prozess des Zersetzens von Plastikmüll durch Bakterien in einem Video symbolisiert dargestellt. Diese interaktive Darstellung dient dazu, das Problem sowie den Widerstand der Natur noch einmal zu verdeutlichen und den Betrachter:innen eine ganzheitliche Erfahrung zu bieten.




Einblicke in die AR-Erweiterung


Kontakt: @philipp.rigaud
The Bee Paradox
Fotografien & Augmented Reality
Vita
Philipp Rigaud ist 25 Jahre alt, in Wien geboren und ein Masterstudent der FH St Pölten in der Masterklasse Fotografie. Seine weiteren Werke können auf Instagramm gefunden werden.
Artist Statement
„Das Thema ‚Widerstand der Natur‘ ist ein schwieriges Thema für mich, da es sehr schwer zu definieren ist. Ist nun die Pflanze, die aus dem Asphaltboden wächst, wirklich Widerstand, oder einfach nur der natürliche Lauf der Dinge. Daher bin ich zu dem Thema der Ignoranz der Menschheit gekommen, aufgrund des Statements von Antoine Magnan, welcher in seiner Einleitung von seinem im Jahr 1934 erschienen Buch «Le vol des Insectes» sagt:
‚Angeregt durch die Aktivitäten auf dem Gebiet der Luftfahrt wandte ich die Gesetze des Luftwiderstands auf die Insekten an und kam, zusammen mit Herrn Sainte-Laguë, zum Schluss, dass ihr Flug unmöglich ist.‘ und dennoch fliegen Insekten und Bienen. Aufgrund dieser Aussage habe ich mir die Aufgabe gesetzt, Bienen im Flug und in ihrer Lebensweise zu fotografieren. Dies habe ich zusammen mit der Wiener Bezirksimkerei gemacht, die mich freundlicherweise zu einem Arbeitstag mitgenommen haben. Dabei sind 5 Bilder entstanden und ausgewählt worden, wobei mein persönlicher Favorit das Foto ist, in dem eine Biene die Zunge zeigt.“
- Philipp Rigaud
Augmented Reality
Mit Augment Reality werden die Bilder aus den Augen der Bienen gezeigt. Dafür ist ein Kaleidoskop Effekt auf die Bilder gelegt worden. Mit AR sollen die Bilder aus dem Auge eines anderen Betrachters dargestellt und somit die Vorstellungskraft des Betrachters erweitert werden.












